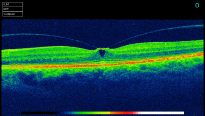
The vitreous (jelly) pulling on the retina

Optical Coherence Tomography (OCT)
A whole new way of examining your eyes
What is OCT?
Optical Coherence Tomography uses low intensity infra-red light to give a 3D image of the back of the eye. It shows not only the surface but also the depth of the structures. It is similar to using ultrasound and creates an image not unlike an MRI or CT scan.
The light levels are very low, the scan takes seconds to acquire and is totally painless. All you need to do is look at a light, keep your eyes still and not blink for two seconds, simple as that!
As well as the 3D scan, our instrument also takes a photograph of the eye in high resolution. This allows us to pin point any area of concern to review in depth.
What are the benefits?
The instrument is incredibly good at measuring and monitoring Macular Degeneration. It can measure the thickness of the optic nerves which are affected by Glaucoma (and compare to an age, gender and ethnically matched normal).
In both circumstances it can mathematically show any changes from one visit to the next, working at a level way beyond the ability of even the most experienced observer with normal viewing methods.
If there are any changes or abnormalities they can be monitored by ourselves if appropriate. Should you need referral to a hospital the information we provide can help immensely in aiding the doctor to prioritise the urgency for assessment/treatment.
Does everyone benefit?
Everyone can have greater reassurance from a more in-depth examination. The two main areas where we see benefits are to people with, or likely to develop, Macular Degeneration (mainly people aged 60 or over) and those with a family history of Glaucoma or high pressures in their eyes. Diabetics can be monitored and compared more accurately, which is very beneficial in the long term.
Do I need to have an OCT scan?
When checking the health of your eye the more information we have the better the quality of our decisions will be. This procedure gives us far more information to make a decision now, and improves our ability to compare and notice very subtle changes in the years to come.
What does OCT cost?
The OCT scan is an additional test and as such is not part of a standard NHS eye test. Should you take advantage of the scan it would be performed before your standard eye test.
The cost is £45.00.
For more information on OCT scans and to book an appointment please phone our practice on:
Newcastle Branch - Tel. 0191 232 1002
Morpeth Branch - Tel. 01670 518 612
3 ways to help protect and maintain a healthy macula.
- Eat a diet rich in vitamins and minerals, particularly Lutein and Zeaxanthin. These are found in green leafy vegetables and in yellow fruits.
- Have regular check-ups including the OCT scan to monitor any changes.
- Protect your eyes against damage from UV light. When buying sunglasses make sure they have adequate UV protection.
More OCT images Download Leaflet

Leaflet - OCT
Leaflet - OCT